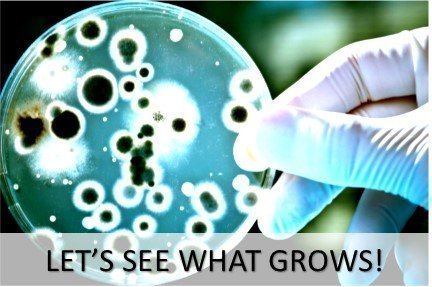

-. Binding : Toy
-. Brand : Diamante Scientific
-. EAN : 0731882163872
-. Feature : ONE OF THE BEST SELLING BACTERIA GROWING SCIENCE FAIR KITS. NOW IMPROVED FOR THE 2017-2018 SCHOOL YEAR SO IT'S SAFER FOR KIDS TO USE. We've included gloves and goggles so you don't have to come in contact with the bacteria that you swab. Each kit includes 10 pre-poured 15x100mm agar plates, 10 cotton swabs, 2 plastic droppers, 1 bottle of hand sanitizer, Latex Gloves, Protective Goggles, simple step-by-step instructions and a free science experiment project guide. / OUR PLATES ARE PRE-POURED. DON'T WASTE TIME POURING AGAR. GET RIGHT TO GROWING BACTERIA. The plates are pre-poured, TSA (Tryptic Soy Agar) / Nutrient Agar. The same nutrient agar used by microbiologists to grow bacteria in the lab. You don't have to pour your own plates which can be time-consuming and sometimes dangerous for kids. / OUR PLATES HAVE A SHELF LIFE OF LONGER THAN ONE YEAR AND ARE MANUFACTURED IN THE USA. Our plates won't crack or dry out. They have a thick layer of agar which promotes good growth, have been professionally packaged and vacuum sealed in level 5 cleanroom for a longer shelf life. THIS PACKAGING PROCESS IS PATENT PROTECTED. / GREAT FOR ENCOURAGING (STEM) SCIENCE, TECHNOLOGY, ENGINEERING, MATHMATICS FOR YOUNG STUDENTS. Ideal for elementary, middle school and high school students. Recommended for age 8 and up with adult supervision.
-. IsAdultProduct : 0
-. Label : Diamante Scientific
-. Manufacturer : Diamante Scientific
-. MPN : LYSB012XZ3DLC-TOYS
-. PackageQuantity : 1
-. PartNumber : LYSB012XZ3DLC-TOYS
-. ProductGroup : Toy
-. ProductTypeName : TOYS_AND_GAMES
-. Publisher : Diamante Scientific
-. Studio : Diamante Scientific
-. Title : Bacteria Science Fair Project Kit. NEWER AND SAFER For School. Great for Students Interested in Learning About Microbiology. Free Project Guide eBook Available.
-. UPC : 731882163872
DIMENSION INFOMATION
Product Dimensions : 27.94(Width) x 31.75(Length) x 2.54(Height) cm
Shipping Weight : 80 Hundredths Pounds